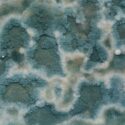

Aydın’ın İncirliova ilçesinde faaliyet gösteren Günaydınlar İncir İşletmesi, ihraç ettiği incirlerde tespit edilen aflatoksin nedeniyle büyük bir krize sürüklendi. Avrupa Birliği ülkelerinden geri dönen ürünler ve ödenemeyen borçlar sonucu şirket iflas etti.
Yaklaşık 280 çalışanı olan işletme sahibi Kazım Günaydın, birçok üreticiden topladığı incirleri işleyerek yurt dışına satıyordu. Ancak ihraç edilen ürünlerde tespit edilen aflatoksin, hem şirketin itibarını zedeledi hem de büyük ekonomik kayıplara neden oldu.

Çalışanlar mağdur oldu
Aflatoksin skandalının ortaya çıkmasıyla birlikte işletme, ciddi finansal sıkıntılar yaşamaya başladı. Çalışanların maaşları ödenemez hale geldi ve işçilerin büyük bir kısmı işten ayrılmak zorunda kaldı. Geriye kalan az sayıda çalışan ise aylarca maaş alamadan çalışmaya devam etti.
Alacaklılar kapıda
Şirketin iflas haberini alan çok sayıda alacaklı, işletmenin kapısına dayandı. Alacaklarını tahsil etmek isteyen alacaklılar, güvenlik güçlerinin müdahalesiyle bölgeden uzaklaştırıldı.
Aflatoksin nedir?
Aflatoksin, belirli küf mantarları tarafından üretilen ve karaciğer kanseri başta olmak üzere birçok hastalığa neden olabilen güçlü bir toksindir. Özellikle fındık, fıstık, badem, mısır ve kurutulmuş meyvelerde sıkça görülür.

Uzmanlar uyarıyor
Gıda güvenliği uzmanları, bu olayın Türkiye’deki tarım ürünlerinin ihracatında kullanılan kalite kontrol sistemlerinin yeniden gözden geçirilmesi gerektiğini belirtiyor. Aflatoksin gibi kontaminantların önlenmesi için üretim süreçlerinde daha sıkı denetimler yapılması ve tüketicilerin bilinçlendirilmesi büyük önem taşıyor.
Bu olay, Türkiye’nin tarım sektöründe yaşanan sorunların bir kez daha gündeme gelmesine neden oldu. Aflatoksin gibi kontaminantların tespiti ve önlenmesi için daha etkili çözümler üretilmesi gerekiyor.
#aflatoksin #incir #gıdaGüvenliği #Türkiye #tarım